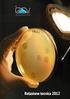
SISTEMA BUFALA DETECTOR BUFALE IDENTIFICATE E TRACCIATE PER UNA PRODUZIONE PIÙ SICURA

Versatile, affidabile, preciso
|
|
|
- Flaviana Morandi
- 9 anni fa
- Просмотров:
Транскрипт
1 Numero 1-2 Anno Via Luigi Dalla Via, Schio (VI) Tel Fax [email protected] - Lettore di banconote Lithos Versatile, affidabile, preciso Indice In questo numero 02 Software BillValidator Nuovo Riconoscitore di monete Caesium Come eseguire il test sul campo Prossimi appuntamenti 2011 Notizie del mondo Notizie Coges Il nuovo lettore di banconote Lithos progettato da Coges presenta innovative soluzioni tecnologiche sia meccaniche che elettroniche per offrire la massima affidabilità nella lettura delle banconote e nella discriminazione dei falsi, qualità e robustezza dei materiali, semplicità di installazione e manutenzione e grande versatilità di utilizzo. Alcune caratteristiche: Protocolli di funzionamento: parallelo, MDB, BCD, impulsi, accept/return, seriale e a blocchi multipli. Tempo medio di incasso inferiore a 2 secondi. Dimensioni delle banconote accettate: da un minimo di 50 x 110 mm ad un massimo di 72 x 160 mm. Numero massimo di memorizzazioni: fino a 100 facce di banconote. Stacker: 300 o 600 banconote. Programmazione tramite chiave USB o collegamento a PC. Bocchetta in alluminio con aggancio rapido
2 Software BillValidator Applicativo indispensabile per la programmazione e la gestione Il software BillValidator è un applicativo indispensabile per la programmazione e la gestione di tutti i Lettori di banconote Coges. Questo software permette, innanzi tutto, la riprogrammazione del Modello impostato nel lettore. Ogni Modello contiene delle impostazioni generali di funzionamento e delle informazioni riguardanti un determinato insieme di banconote; è possibile programmare il Lettore di banconote utilizzando uno dei Modelli preimpostati o creandone uno nuovo. BillValidator permette inoltre importanti operazioni di manutenzione ed analisi dello stato (polling), finalizzate a verificare il corretto funzionamento del dispositivo, così da garantirne sempre la massima efficienza. Un altra delle principali funzionalità di BillValidator è la creazione e gestione di un archivio di banconote e un archivio di modelli di banconote. Questo permette la massima flessibilità nel creare configurazioni personalizzabili che, una volta trasferite sul Lettore, definiscono quali banconote deve essere in grado di accettare. In questo modo, il Gestore può adattare il proprio Lettore di banconote alle valute desiderate, impiegandolo in diversi mercati. Questa programmazione può avvenire tramite collegamento diretto del Lettore al Personal Computer o per mezzo del programmatore portatile Maxi Programmer. L Archivio Banconote comprende una vasto database di banconote già acquisite da Coges, appartenenti a molte differenti valute, così da poter garantire un ampia versatilità nell utilizzo del dispositivo. Questo database viene tenuto costantemente aggiornato da Coges, che ne rilascia periodicamente nuove versioni liberamente scaricabili da parte dei nostri clienti presso l area Download del sito eu. BillValidator consente all utente anche la possibilità di acquisire da sé dei campioni di banconota, nel caso queste non fossero ancora presenti nel database. Tutte le informazioni presenti in Archivio, naturalmente, possono essere protette tramite l applicazione di password e possono essere salvate in apposite copie di backup per limitare la possibilità di perdita dei dati. BillValidator è disponibile in sei lingue (italiano, inglese, francese, tedesco, spagnolo e portoghese) e supporta i lettori di banconote Eureka, il TP606 ed il nuovo lettore Lithos. Una funzione di BillValidator che forse non tutti conoscono è la possibilità di visualizzare un immagine delle diverse banconote presenti in Archivio, associata alla relativa faccia della banconota. Per attivare questa funzione è sufficiente scaricare dal sito web Coges l archivio di immagini, BillValidator Images, ed installarlo nella stessa directory di BillValidator. A partire dalla versione 1.71, BillValidator supporta anche il trasferimento del Modello su chiave USB, così da poterlo trasferire velocemente sui lettori di banconote Lithos. 02
3 Nuovo Riconoscitore di monete Caesium Design modulare Attraverso il PC con il software EasyCoinCaesium è possibile cambiare il modello scegliendo fra quelli messi a disposizione da Coges o modificare quello utilizzato ad esempio programmando nuovi gettoni per la vendita. La presenza del microprocessore Flash, nella scheda di controllo del Riconoscitore di monete, permette l aggiornamento del firmware senza alcuna sostituzione hardware, garantendo così la massima efficienza del dispositivo. Dotato di sistema anti-fishing in ingresso (meccanico e ottico), il Riconoscitore Caesium è in grado di contrastare eventuali tentativi di ripescaggio delle monete introdotte. Il nuovo riconoscitore Caesium è stato progettato con struttura modulare per una rapida sostituzione del modulo sensori e del modulo di uscita. La programmazione dei principali parametri di funzionamento può avvenire attraverso il dip-switch Il nuovo Riconoscitore di monete Caesium per le sue caratteristiche dimensionali, di versatilità, affidabilità e robustezza, è particolarmente adatto per l installazione su distributori automatici di piccole dimensioni. Semplici operazioni di programmazione garantiscono al Riconoscitore la massima flessibilità facendone, a tutti gli effetti, un prodotto plurifunzionale. Caesium è perfettamente intercambiabile rispetto al precedente Riconoscitore UR3 Coges ed è in grado di memorizzare 32 diversi tipi di monete e/o gettoni. Il riconoscimento delle monete avviene per mezzo di un raffronto delle loro caratteristiche fisiche, le caratteristiche di lega e le dimensioni fisiche. Le misure rilevate al passaggio della moneta vengono poi confrontate con il modello memorizzato in fase di programmazione. Le monete che non risultano conformi alle caratteristiche programmate, vengono convogliate verso l esterno e restituite all utente; le monete considerate valide, invece, vengono incassate. In fase di collaudo nel microprocessore del Riconoscitore Caesium viene memorizzato un modello con particolari caratteristiche: Nazione, monete accettate, monete memorizzate ma inibite, tipo di uscita desiderata e valore dell uscita associata alla moneta programmata. esterno, mentre la programmazione completa del riconoscitore avviene attraverso PC collegato attraverso un interfaccia seriale. Il Riconoscitore può essere installato nel distributore in due differenti modalità: installazione con piastra frontale direttamente sul distributore; installazione all interno della gettoniera con apposito adattatore 5 pollici. Il nuovo riconoscitore Caesium è dotato di due tipi di piastra frontale, fornite come accessori, nella versione MINI (più piccola e compatta) e MIDI (più grande e compatibile con la precedente versione per EUR3). 03
4 Nuovo Riconoscitore di monete Caesium Design modulare DATI TECNICI Dimensioni Peso Accettazione Numero monete riprogrammabili Diametro massimo monete Dimaetro minimo monete Spessore monete Velocità max di accettazione Programmazione Range di alimentazione 89 x 49 x 103 mm 175 gr. 32 monete 2 Ø 28 mm Ø 16 mm de 1 a 3,2 mm 3 monete/sec tramite PC e Dipswitch 12/24 V DC (32 V DC Max) Valori programmabili 32 Range di temperatura 0-50 º C Potenza assorbita (a riposo) 1 W Potenza massima assorbita 6 W Direttiva Compatibilità Elettromagnetica 2004/108 CE 04
5 Come eseguire il test sul campo Il field test, la prova sul campo di un prodotto appena realizzato prima di proporlo sul mercato, non è certo una novità per Coges. Già da diversi anni, come sanno molti clienti Coges, questo tipo di test si affianca a quelli condotti in laboratorio dai nostri tecnici al fine di osservare come si comporta il prodotto in situazioni di utilizzo normale e quotidiano, difficili se non impossibili da riprodurre artificialmente. In molti casi il primo campo di prova è naturalmente Coges stessa, dove nel corso degli anni i dipendenti hanno potuto sperimentare in anteprima il funzionamento dei diversi sistemi di pagamento cashless, gettoniere rendiresto, lettori di banconote ed accessori che hanno poi arricchito la nostra gamma di prodotti. Quello che potrebbe magari essere visto come un piccolo fastidio per i dipendenti, ad esempio l invito per un certo periodo ad usare il contante, è correttamente interpretato invece come la possibilità di offrire un semplice ma prezioso contributo al perfezionamento del prodotto e magari alla scoperta di problemi che in precedenza non erano emersi, permettendo di offrire ai clienti una versione già ottimizzata. Proprio perché questa pratica è diffusa in azienda da molto tempo, tutti i dipendenti sono anche abituati a segnalare ai tecnici eventuali comportamenti sospetti dei dispositivi chiedendo spiegazioni, suggerendo possibili miglioramenti e fornendo un primo giudizio sulle caratteristiche funzionali del prodotto, assumendo così l utile ruolo di un ufficio test diffuso. I tecnici della Ricerca e Sviluppo allo stesso tempo hanno la possibilità di usufruire di dati sperimentali anche sui prodotti più innovativi e di intervenire immediatamente qualora dovessero presentarsi delle anomalie, studiando possibili soluzioni e alternative senza coinvolgere i clienti. Inoltre, successivamente o in parallelo ai test condotti in azienda, spesso vengono coinvolti anche alcuni clienti ai quali viene chiesto di installare e provare i nuovi prodotti per un breve periodo di tempo, avvalendosi della loro consulenza critica. In questo modo l affidabilità del field test aumenta in modo considerevole perché crescono sia la quantità dei dati raccolti che la varietà delle situazioni in cui il dispositivo si trova ad operare: dalle decine di dipendenti Coges si passa a centinaia di utenti in tutta Italia ed in Europa e dai pochi distributori automatici presenti in azienda ci si trova ad avere a che fare con molti modelli diversi operanti con protocolli differenti. Nel corso del field test il servizio Post Vendita, sempre in contatto diretto con i clienti che partecipano al test, fornisce subito la prima assistenza sempre utile nel caso di nuovi prodotti e raccoglie tutte le informazioni rilevate sul campo per passarle all ufficio Ricerca e Sviluppo, che anche in questo caso può intervenire per perfezionare il prodotto. Le prove sul campo in questo modo sono in grado di rivelare perfettamente vantaggi, preferenze e problemi, rappresentando la parte più importante della prova specialmente per prodotti completamente nuovi. In questo momento Coges si sta avvalendo dell insostituibile collaborazione di diversi clienti per testare sul campo le funzionalità del nuovo lettore di banconote Lithos e del nuovo riconoscitore di monete Caesium, che andranno presto ad aggiungersi alla vasta famiglia dei prodotti Coges per il riconoscimento dei contanti. 05
6 Prossimi appuntamenti 2011 Sono già molte le fiere internazionali a cui Coges ha avuto il piacere di partecipare nel 2011, presentando al pubblico la gamma completa dei propri prodotti inclusi il Platinum MIFARE, le gettoniere Aeterna e PROFIT, il modulo per la telemetria Comunica ed il nuovo lettore di banconote Lithos. Tra le più importanti in cui Coges si è presentata ricordiamo JDA a Marsiglia, VendExpo a Mosca insieme al nuovo rivenditore Professional and Vending Machines, Vending Benelux ad Antwerp e la più recente Avex a Birmingham con il nostro partner Coffetek. Tutti questi eventi sono stati caratterizzati da una partecipazione molto buona e da grande interesse nei confronti di Coges e dei suoi prodotti. I prossimi appuntamenti: Eu Vend e Vendiberica Dall 8 al 10 Settembre 2011 Eu Vend aprirà i suoi battenti a Colonia per la quinta volta. Con una partecipazione internazionale di espositori del 34% ed una partecipazione internazionale di visitatori di quasi il 40%, Eu Vend dimostra perché sarà la fiera di riferimento per il settore del Vending in Europa nel Coges sarà presente allo stand 8.1 A28 B29 per presentare il nuovo lettore di banconote Lithos ed il nuovo riconoscitore di monete Caesium. Per ogni tipo di informazione visitate il sito: Fiera del Vending si svolgerà da Lunedì 21 a Mercoledì 23 novembre presso il Parque Ferial Juan Carlos I di Madrid, in coincidenza con la quinta edizione di Horeq. VENDIBERICA nasce dalla necessità di una fiera appositamente per il settore della distribuzione automatica, con l obiettivo di promuovere la crescita del settore e di affermarsi come l evento di punta della penisola (Spagna e Portogallo). VENDIBERICA si propone comel evento più importante dell anno per il settore ed un punto di incontro fondamentale per i professionisti del mondo del Vending. Per ogni tipo di informazione visitate il sito: 06
7 Notizie del mondo Eggmachine - La campagna di Pasqua NOAH Il centro di Francoforte (presso la stazione principale). Si tratta di Martedì 12 Aprile Poco prima di Pasqua. Mentre tutti i negozi sono pieni di uova, in mezzo al caos ed alla frenesia dello shopping l attenzione è attirata da uno straordinario distributore automatico da cui è possibile acquistare uova, uova fresche da galline vere. Il distributore di uova! Attrae gente anche da lontano. I bambini chiedono stupiti: Papà, guarda, i polli sono veri? Sì, lo sono! 16 galline reali in tutta la loro gloria, messi lì da Ansgar Vortmann, allevatore di polli da riproduzione, fortunatamente solo per qualche ora e senza arrecare loro nessun danno. I polli sono stati tenuti sotto sorveglianza in una macchina modificata, per un periodo di tempo molto breve Lo scopo di questa operazione, messa in atto dall associazione ambientalista tedesca NOAH, era quello di attirare l attenzione non solo sulle condizioni di vita assolutamente inaccettabili delle galline allevate in batteria, ma anche per convincere PepsiCo introduce Social Vending System, il distributore automatico social Dopo i social network arriva dall America anche il social Vending: PepsiCo, azienda produttrice della nota bevanda, ha presentato al NAMA di Chicago il lancio del suo Social Vending System. Si tratta di un distributore collegato in rete che consente ai consumatori di offrire una bibita in regalo ad un amico, selezionandola sul distributore ed inserendo il nome del destinatario, il suo numero di telefono ed un messaggio personalizzato. Sul telefono del destinatario apparirà quindi un messaggio con un codice i consumatori ad acquistare solo uova che provengono da animali allevati a terra. Anche se tra lo stupore di tutti i passanti il distributore di uova sembrava un vero distributore di snack, naturalmente non era possibile inserire davvero le monete ed acquistare le uova. Queste venivano invece distribuite dalla squadra di promozione di NOAH assieme a dei volantini con l invito a CONTROLLARE L UOVO informandosi sui quattro diversi sistemi di allevamento delle galline, che la gente dovrebbe usare come guida ai prossimi acquisti di. La azione di NOAH è stata accolta con grande interesse. Oltre a numerosi passanti che hanno fotografato il distributore di uova con i telefoni cellulari, contribuendo a diffondere in tutto il mondo informazioni sugli abusi sui polli, molti rappresentanti dei media erano presenti personalmente per scattare foto. Le 16 galline sono intanto tornate nel cortile, felici come non mai e in perfetta salute! Per maggiori informazioni visitate il sito: e le istruzioni per incassare il regalo presso qualsiasi distributore Social Vending System, con la possibilità di ricambiare a sua volta il regalo o di offrire da bere a qualcun altro. Sarà anche possibile personalizzare ulteriormente il regalo con un breve video registrato presso il distributore. Che dire? Una volta per offrire da bere a qualcuno bisognava se non altro essere fisicamente presenti, ma i tempi cambiano 07
8 Notizie Coges Ferie estive 2011 Vi informiamo che Coges rimarrà chiusa per ferie da Lunedì 01/08/2011 a Lunedì 22/08/2011 inclusi. Gli uffici rimarranno chiusi da Lunedì 08/08/2011 a Lunedì 22/08/11 inclusi. Il post vendita Coges sarà disponibile dall 8 al 12 Agosto (09:00 / 12:00 e 14:00 / 17:00) al numero Coges augura a tutti buone vacanze! Nuovo centralino automatico Da qualche mese è attivo in Coges un nuovo centralino automatico che riceve e smista le chiamate provenienti dall esterno. Dopo aver composto il familiare numero di telefono (preceduto dal prefisso 0039 per le chiamate dall estero) la voce registrata inviterà l interlocutore a premere il pulsante 1 per parlare direttamente con un tecnico del servizio Post Vendita, 2 per essere messi in contatto con una persona dell Area Commerciale o 3 per parlare con l Ufficio Acquisti. In ognuno di questi casi, risponderà al telefono la prima persona disponibile nell ufficio desiderato. Infine, in caso di dubbio si può premere il pulsante 9 per parlare con un operatore che vi metterà in contatto con la persona più indicata alle vostre esigenze. Cogliamo l occasione per rivolgere un caro saluto ed un ringraziamento a Monica, che per molti anni è stata addetta alla reception Coges. Caesium, efficienza certificata. La tecnologia di lettura digitale (DSP, Digital Signal Processor) utilizzata nel nuovo riconoscitore di monete Caesium ha superato con successo i test dalla Deutsche Bundesbank (Banca Centrale Tedesca) per il riconoscimento delle monete inserite e la discriminazione dei falsi nell area Euro. Coges S.p.A. Via Luigi Dalla Via, SCHIO (VI) Italy. Tel Fax [email protected] - Skype coges_ita Cod. Fisc. - R.I. VICENZA P.I. IT Registro A.E.E. IT C.C.I.A.A. VICENZA - R.E.A M.E. VI C.S.I.V /00 Azionista Unico: Azkoyen Medios de Pago S.A. (Gruppo Azkoyen - Peralta/Navarra/Spagna) Direzione e Coordinamento: Azkoyen S.A. (Gruppo Azkoyen - Peralta/Navarra/Spagna)
COGES ONLINE WEB HOSTING Presentazione
 COGES ONLINE WEB HOSTING Presentazione PROFILO COGES S.P.A. experience + innovation 2 PROFILO AZIENDALE PUNTI CHIAVE Coges progetta, produce e offre al mercato una gamma completa di sistemi di pagamento
COGES ONLINE WEB HOSTING Presentazione PROFILO COGES S.P.A. experience + innovation 2 PROFILO AZIENDALE PUNTI CHIAVE Coges progetta, produce e offre al mercato una gamma completa di sistemi di pagamento
BTDATAKEY COMPATIBILITÀ PRODOTTI
 BTDATAKEY COMPATIBILITÀ PRODOTTI 2 SISTEMI CASHLESS SCHEDA A CONTATTI MODIFICATA Irda esterna: IR DataKey Compatibilità BTDataKey: Non testata Altri dati identificativi: Scheda elettronica modificata con
BTDATAKEY COMPATIBILITÀ PRODOTTI 2 SISTEMI CASHLESS SCHEDA A CONTATTI MODIFICATA Irda esterna: IR DataKey Compatibilità BTDataKey: Non testata Altri dati identificativi: Scheda elettronica modificata con
AGGIORNAMENTO E PROGRAMMAZIONE LETTORI DI BANCONOTE EUREKA
 LETTORI EUREKA AGGIORNABILI CON LE NUOVE BANCONOTE EURO: Alcuni lettori di banconote Eureka sono dotati di tecnologia flash che ne permette l'aggiornamento sia della versione firmware che del Database
LETTORI EUREKA AGGIORNABILI CON LE NUOVE BANCONOTE EURO: Alcuni lettori di banconote Eureka sono dotati di tecnologia flash che ne permette l'aggiornamento sia della versione firmware che del Database
Imagicle Hotel. Guida alla configurazione delle centrali Elmeg
 Imagicle Hotel. Guida alla configurazione delle centrali Elmeg 2016 01/03/2016 2-17 www.imagicle.com Indice 1 CENTRALI ELMEG SUPPORTATE.... 5 2 PRINCIPI DI FUNZIONAMENTO.... 6 3 INSTALLAZIONE E CONFIGURAZIONE
Imagicle Hotel. Guida alla configurazione delle centrali Elmeg 2016 01/03/2016 2-17 www.imagicle.com Indice 1 CENTRALI ELMEG SUPPORTATE.... 5 2 PRINCIPI DI FUNZIONAMENTO.... 6 3 INSTALLAZIONE E CONFIGURAZIONE
Software EasyTool Professional
 Il software EasyTool Professional consente di effettuare, attraverso il PC, tutte le operazioni di configurazione, programmazione e manutenzione del sistema By-me in alternativa alla centrale. L applicativo
Il software EasyTool Professional consente di effettuare, attraverso il PC, tutte le operazioni di configurazione, programmazione e manutenzione del sistema By-me in alternativa alla centrale. L applicativo
Antintrusione Serie SPC: la soluzione migliore in ambito sicurezza per le persone, beni e proprietà. Il futuro è già oggi.
 Antintrusione Serie SPC: la soluzione migliore in ambito sicurezza per le persone, beni e proprietà. Il futuro è già oggi. Answers for infrastructure. Le cose cambiano, ma le necessità di sicurezza restano.
Antintrusione Serie SPC: la soluzione migliore in ambito sicurezza per le persone, beni e proprietà. Il futuro è già oggi. Answers for infrastructure. Le cose cambiano, ma le necessità di sicurezza restano.
ATLAS II/E/M. Distributore di schede magnetiche e microchip
 ATLAS II/E/M Distributore di schede magnetiche e microchip M.D.S Electronics Srl Viale Certosa 131 20151 Milano Tel. 02 38002318- Fax 02 38007903 e-mail: [email protected] www.mdsonline.it Indice INTRODUZIONE...3
ATLAS II/E/M Distributore di schede magnetiche e microchip M.D.S Electronics Srl Viale Certosa 131 20151 Milano Tel. 02 38002318- Fax 02 38007903 e-mail: [email protected] www.mdsonline.it Indice INTRODUZIONE...3
Imagicle Hotel. Guida alla configurazione del modulo optipoint Siemens
 Imagicle Hotel. Guida alla configurazione del modulo optipoint Siemens 2016 01/03/2016 2-12 www.imagicle.com Indice 1 CENTRALI SIEMENS SUPPORTATE.... 5 2 PRINCIPI DI FUNZIONAMENTO.... 6 3 CONFIGURARE BLUE
Imagicle Hotel. Guida alla configurazione del modulo optipoint Siemens 2016 01/03/2016 2-12 www.imagicle.com Indice 1 CENTRALI SIEMENS SUPPORTATE.... 5 2 PRINCIPI DI FUNZIONAMENTO.... 6 3 CONFIGURARE BLUE
SISTEMA DI CONTROLLO E GESTIONE STAZIONI DI RICARICA E-CORNER PER VEICOLI ELETTRICI
 1/10 SISTEMA DI CONTROLLO E GESTIONE STAZIONI DI RICARICA E-CORNER PER VEICOLI ELETTRICI 2/10 ARCHITETTURA DI SISTEMA Il sistema è basato su una rete di stazioni di ricarica, con configurazione e tipologia
1/10 SISTEMA DI CONTROLLO E GESTIONE STAZIONI DI RICARICA E-CORNER PER VEICOLI ELETTRICI 2/10 ARCHITETTURA DI SISTEMA Il sistema è basato su una rete di stazioni di ricarica, con configurazione e tipologia
Manuale istruzioni. Interfaccia USB art Manuale per l'installatore
 Manuale istruzioni Interfaccia USB art. 01540 Manuale per l'installatore Indice CARATTERISTICHE GENERALI E FUNZIONALITA' da pag. 5 OGGETTI DI COMUNICAZIONE, PARAMETRI ETS E FAQ da pag. 6 OGGETTI DI COMUNICAZIONE
Manuale istruzioni Interfaccia USB art. 01540 Manuale per l'installatore Indice CARATTERISTICHE GENERALI E FUNZIONALITA' da pag. 5 OGGETTI DI COMUNICAZIONE, PARAMETRI ETS E FAQ da pag. 6 OGGETTI DI COMUNICAZIONE
Bilanciatevi. Misuratevi. Distinguetevi.
 Bilanciatevi. Misuratevi. Distinguetevi. La misura della professionalità Design e innovazione. Con un design accattivante e moderno Pesofarma 4 si presenta, non solo come una bilancia multifunzione, ma
Bilanciatevi. Misuratevi. Distinguetevi. La misura della professionalità Design e innovazione. Con un design accattivante e moderno Pesofarma 4 si presenta, non solo come una bilancia multifunzione, ma
Coges a Venditalia, vi aspettiamo!
 Numero 2-2012 Via Luigi Dalla Via, 10-36015 Schio (VI) Tel. 0445 502811 - Fax 0445 502999 E-mail [email protected] - www.coges.eu Indice 02 03 04 05 06 07 08 In questo numero Coges Engine Pagare con il cellulare
Numero 2-2012 Via Luigi Dalla Via, 10-36015 Schio (VI) Tel. 0445 502811 - Fax 0445 502999 E-mail [email protected] - www.coges.eu Indice 02 03 04 05 06 07 08 In questo numero Coges Engine Pagare con il cellulare
MyCashUp Cassa su Tablet Android o Apple. MyCashUp
 MyCashUp Cassa su Tablet Android o Apple MyCashUp è il nuovo registratore di cassa sul tuo tablet o smartphone, Android o Apple. Soluzione semplice e intuitiva da Caronni srl partner Lasersoft Semplice
MyCashUp Cassa su Tablet Android o Apple MyCashUp è il nuovo registratore di cassa sul tuo tablet o smartphone, Android o Apple. Soluzione semplice e intuitiva da Caronni srl partner Lasersoft Semplice
TERMINALE DI RILEVAZIONE PRESENZE E CONTROLLO ACCESSI CON LETTORE DI IMPRONTE DIGITALI E TESSERE RFID, MOD. SVAR2-FINGER
 TERMINALE DI RILEVAZIONE PRESENZE E CONTROLLO ACCESSI CON LETTORE DI IMPRONTE DIGITALI E TESSERE RFID, MOD. SVAR2-FINGER 1 SVAR2-FINGER è un terminale di rilevazione presenze e controllo accessi elegante,
TERMINALE DI RILEVAZIONE PRESENZE E CONTROLLO ACCESSI CON LETTORE DI IMPRONTE DIGITALI E TESSERE RFID, MOD. SVAR2-FINGER 1 SVAR2-FINGER è un terminale di rilevazione presenze e controllo accessi elegante,
Chiusura elettronica Genialmente sicuro. Genialmente semplice.
 Sicurezza confortevole. Ideale per porte private, professionali e collettive. Genialmente sicuro. Genialmente semplice. www.burg.biz La combinazione perfetta tra sicurezza e semplicità. Ideale per porte
Sicurezza confortevole. Ideale per porte private, professionali e collettive. Genialmente sicuro. Genialmente semplice. www.burg.biz La combinazione perfetta tra sicurezza e semplicità. Ideale per porte
07/12-01 PC Lettore di Prossimità Sfera. Manuale installatore
 07/12-01 PC 353200 Lettore di Prossimità Sfera Manuale installatore 2 Lettore di Prossimità Sfera Indice 1 Introduzione 4 1.1 Avvertenze e consigli 4 Manuale installatore 2 Descrizione 5 2.1 Funzioni principali
07/12-01 PC 353200 Lettore di Prossimità Sfera Manuale installatore 2 Lettore di Prossimità Sfera Indice 1 Introduzione 4 1.1 Avvertenze e consigli 4 Manuale installatore 2 Descrizione 5 2.1 Funzioni principali
Importata e distributa da: JACKOBS SRLs Sede Operativa: Via Lavoratori Autobianchi 1, Desio (MB)
 Tel 346 1836051 skype: massimo.seccardelli e_mail: [email protected] Tel 392 2073899 skype: andrea-castrogiovanni e_mail: [email protected] 1 Nata negli USA, a Corbondale (Colorado), si
Tel 346 1836051 skype: massimo.seccardelli e_mail: [email protected] Tel 392 2073899 skype: andrea-castrogiovanni e_mail: [email protected] 1 Nata negli USA, a Corbondale (Colorado), si
Interfaccia 2 FILI / IP
 SCHEDE TECNICHE Interfaccia FILI / IP Descrizione Interfaccia FILI/IP in custodia modulare 10 DIN. Consente la realizzazione di impianti misti FILI /IP molto estesi e con un elevato numero di dispositivi
SCHEDE TECNICHE Interfaccia FILI / IP Descrizione Interfaccia FILI/IP in custodia modulare 10 DIN. Consente la realizzazione di impianti misti FILI /IP molto estesi e con un elevato numero di dispositivi
Scheda tecnica online. FLOWSIC150 Carflow FLUSSO VOLUMETRICO-DISPOSITIVI DI MISURAZIONE
 Scheda tecnica online FLOWSIC150 Carflow A B C D E F H I J K L M N O P Q R S T Informazioni per l'ordine Tipo FLOWSIC150 Carflow Cod. art. Su richiesta Le specifiche del dispositivo e i dati relativi alle
Scheda tecnica online FLOWSIC150 Carflow A B C D E F H I J K L M N O P Q R S T Informazioni per l'ordine Tipo FLOWSIC150 Carflow Cod. art. Su richiesta Le specifiche del dispositivo e i dati relativi alle
MANUALE PER L OPERATORE Versione software: 1.0
 Sesto S. Giovanni - 19 Maggio 2004 Div. elettronica DATAFLOW Rev.1.0 SW-HW:DATALINK SOFTWARE PER L ELABORAZIONE DEI SEGNALI RILEVATI DALLA SCHEDA DI ACQUISIZIONE MANUALE PER L OPERATORE Versione software:
Sesto S. Giovanni - 19 Maggio 2004 Div. elettronica DATAFLOW Rev.1.0 SW-HW:DATALINK SOFTWARE PER L ELABORAZIONE DEI SEGNALI RILEVATI DALLA SCHEDA DI ACQUISIZIONE MANUALE PER L OPERATORE Versione software:
HSL OR. Essegibi - HSL OR - User s Manual COD Descrizione
 COD. 100052 1. Descrizione HSL è una prodotto che permette di controllare a distanza il vostro impianto domotico e/o antintrusione mediante webserver www.eb2home.com oppure localmente mediante panel PC
COD. 100052 1. Descrizione HSL è una prodotto che permette di controllare a distanza il vostro impianto domotico e/o antintrusione mediante webserver www.eb2home.com oppure localmente mediante panel PC
Installazione e configurazione DSFPA (Datasoftware Fattura Pubblica Amministrazione)
 Installazione e configurazione DSFPA (Datasoftware Fattura Pubblica Amministrazione) L installazione del software DSFPA avviene in linea generale in due momenti: 1) Installazione lato server, in cui viene
Installazione e configurazione DSFPA (Datasoftware Fattura Pubblica Amministrazione) L installazione del software DSFPA avviene in linea generale in due momenti: 1) Installazione lato server, in cui viene
Come aggiornare il firmware sulle stampanti largo formato
 Come aggiornare il firmware sulle stampanti largo formato Canon imageprograf Introduzione Nella vita di una stampante ImagePrograf, possono essere rilasciati nuove versioni di firmware con l intento di
Come aggiornare il firmware sulle stampanti largo formato Canon imageprograf Introduzione Nella vita di una stampante ImagePrograf, possono essere rilasciati nuove versioni di firmware con l intento di
LETTERA D ACCOMPAGNAMENTO
 LETTERA D ACCOMPAGNAMENTO AVVERTENZE Per chi installa da una release 3.2, poiché la procedura d installazione è stata completamente rivista, è vivamente consigliato contattare un consulente applicativo
LETTERA D ACCOMPAGNAMENTO AVVERTENZE Per chi installa da una release 3.2, poiché la procedura d installazione è stata completamente rivista, è vivamente consigliato contattare un consulente applicativo
CATALOGO GENERALE 2015/2016 INTEGRAZIONE AUTOMATION BUILDING ANTINTRUSIONE FILARE ANTINTRUSIONE WIRELESS ANTINCENDIO DIGITALE CONVENZIONALE
 C A T A L O G O G E N E R A L E 402 ACCESSORI TRASMISSIONI VIDEO HD-SDI AHD IP RILEVAZIONE GAS INTRODUZIONE ALLA COASSIALE STAND ALONE CONVENZIONALE DIGITALE FILARE INTEGRAZIONE BUILDING AUTOMATION KIT
C A T A L O G O G E N E R A L E 402 ACCESSORI TRASMISSIONI VIDEO HD-SDI AHD IP RILEVAZIONE GAS INTRODUZIONE ALLA COASSIALE STAND ALONE CONVENZIONALE DIGITALE FILARE INTEGRAZIONE BUILDING AUTOMATION KIT
TERMINALE DI RILEVAZIONE PRESENZE CON LETTORE DI TESSERE DI PROSSIMITA RFID, MOD. SVAR1-RFID CON DOPPIA BATTERIA E ADATTATORE WI-FI ESTERNO
 TERMINALE DI RILEVAZIONE PRESENZE CON LETTORE DI TESSERE DI PROSSIMITA RFID, MOD. SVAR1-RFID CON DOPPIA BATTERIA E ADATTATORE WI-FI ESTERNO 1 SVAR1-RFID è un terminale di rilevazione presenze elegante,
TERMINALE DI RILEVAZIONE PRESENZE CON LETTORE DI TESSERE DI PROSSIMITA RFID, MOD. SVAR1-RFID CON DOPPIA BATTERIA E ADATTATORE WI-FI ESTERNO 1 SVAR1-RFID è un terminale di rilevazione presenze elegante,
CM Storm presenta Trooper, il case Full Tower dedicato ai gamers piu esigenti: un vero arsenale mobile con caratteristiche modulari.
 Cooler Master azienda leader da diversi anni nella realizzazione di componenti per PC, è lieta di presentare, il case Full Tower dedicato ai gamers piu esigenti: un vero arsenale mobile con caratteristiche
Cooler Master azienda leader da diversi anni nella realizzazione di componenti per PC, è lieta di presentare, il case Full Tower dedicato ai gamers piu esigenti: un vero arsenale mobile con caratteristiche
INSTALLAZIONE E CONFIGURAZIONE DEL SERVIZIO SAFEBOX
 INSTALLAZIONE E CONFIGURAZIONE DEL SERVIZIO SAFEBOX Prerequisiti Passo 1: configurazione di Cliens GSL\Redigo Passo 2: installazione del servizio SafeBox. Elenco e stato dei backup Interazione con Cliens
INSTALLAZIONE E CONFIGURAZIONE DEL SERVIZIO SAFEBOX Prerequisiti Passo 1: configurazione di Cliens GSL\Redigo Passo 2: installazione del servizio SafeBox. Elenco e stato dei backup Interazione con Cliens
[SX MINI ML CLASS] 1. Importato e distribuito da Amico Svapo Srl Via Romolo e Remo Napoli - Tel P.
![[SX MINI ML CLASS] 1. Importato e distribuito da Amico Svapo Srl Via Romolo e Remo Napoli - Tel P. [SX MINI ML CLASS] 1. Importato e distribuito da Amico Svapo Srl Via Romolo e Remo Napoli - Tel P.](/thumbs/48/24733433.jpg) [SX MINI ML CLASS] 1 [SX MINI ML CLASS] 2 Grazie per aver scelto il SXmini ML Class! Per garantire la sicurezza e l'uso corretto, si prega di consultare i diagrammi inclusi e leggere attentamente questo
[SX MINI ML CLASS] 1 [SX MINI ML CLASS] 2 Grazie per aver scelto il SXmini ML Class! Per garantire la sicurezza e l'uso corretto, si prega di consultare i diagrammi inclusi e leggere attentamente questo
Nokia Nseries PC Suite 2.1. Edizione 1
 Nokia Nseries PC Suite 2.1 Edizione 1 2008 Nokia. Tutti i diritti sono riservati. Nokia, Nokia Connecting People e Nseries sono marchi o marchi registrati di Nokia Corporation. Nokia tune è una tonalità
Nokia Nseries PC Suite 2.1 Edizione 1 2008 Nokia. Tutti i diritti sono riservati. Nokia, Nokia Connecting People e Nseries sono marchi o marchi registrati di Nokia Corporation. Nokia tune è una tonalità
USB 3.0 TO SATA ADAPTER ADATTATORE HARD DISK CON FUNZIONE OTB
 USB 3.0 TO SATA ADAPTER ADATTATORE HARD DISK CON FUNZIONE OTB MANUALE UTENTE XU3SATA www.hamletcom.com Gentile Cliente, La ringraziamo per la fiducia riposta nei nostri prodotti. La preghiamo di seguire
USB 3.0 TO SATA ADAPTER ADATTATORE HARD DISK CON FUNZIONE OTB MANUALE UTENTE XU3SATA www.hamletcom.com Gentile Cliente, La ringraziamo per la fiducia riposta nei nostri prodotti. La preghiamo di seguire
Manuale istruzioni. art Manuale per l'installatore
 Manuale istruzioni art. 01547 Manuale per l'installatore Indice CARATTERISTICHE GENERALI da pag. 5 FUNZIONALITA' da pag. 6 FUNZIONALITÀ CARATTERISTICHE GENERALI Per tutti i dettagli relativi al sistema
Manuale istruzioni art. 01547 Manuale per l'installatore Indice CARATTERISTICHE GENERALI da pag. 5 FUNZIONALITA' da pag. 6 FUNZIONALITÀ CARATTERISTICHE GENERALI Per tutti i dettagli relativi al sistema
SLIMPARK
 IT www.designa.it 3 Intro Parcheggiare con stile. Uno spiccato orientamento al futuro e la costante ricerca di novità ci aiutano da oltre 65 anni a sviluppare prodotti e servizi innovativi nella gestione
IT www.designa.it 3 Intro Parcheggiare con stile. Uno spiccato orientamento al futuro e la costante ricerca di novità ci aiutano da oltre 65 anni a sviluppare prodotti e servizi innovativi nella gestione
COPYTEX LA CHIP-CARD. IL TERMINALE. UN SISTEMA.
 LA CHIP-CARD. IL TERMINALE. UN SISTEMA. COPYTEX Pagare copie e stampe con la chip-card. Il sistema di pagamento per copy shop, per istituzioni scolastiche e per aziende. IL SISTEMA DI PAGAMENTO PER COPIA
LA CHIP-CARD. IL TERMINALE. UN SISTEMA. COPYTEX Pagare copie e stampe con la chip-card. Il sistema di pagamento per copy shop, per istituzioni scolastiche e per aziende. IL SISTEMA DI PAGAMENTO PER COPIA
Guida di installazione
 Il braccio destro per il business. Guida di installazione Il termine Wi-Fi è un marchio registrato della Wi-Fi Alliance. Complimenti per aver acquistato il servizio Wi-Fi Space di Impresa Semplice. Di
Il braccio destro per il business. Guida di installazione Il termine Wi-Fi è un marchio registrato della Wi-Fi Alliance. Complimenti per aver acquistato il servizio Wi-Fi Space di Impresa Semplice. Di
Possibili accessori. Avvertenze:
 Lince Italia SpA Azienda con sistema di gestione per la qualità certificato REG. N. 4796 UNI EN ISO 9001:2000 Vers. 170507030707 Rev 2 MANUALE DI ISTALLAZIONE PROGRAMMAZIONE ED USO Art 1660 forza di sollevamento
Lince Italia SpA Azienda con sistema di gestione per la qualità certificato REG. N. 4796 UNI EN ISO 9001:2000 Vers. 170507030707 Rev 2 MANUALE DI ISTALLAZIONE PROGRAMMAZIONE ED USO Art 1660 forza di sollevamento
Un unico sistema per ogni esigenza. CECOFLEX e CECOFLEX Plus sistemi di cablaggio flessibili. e multimediali più importanti dello spazio abitativo.
 Un unico sistema per ogni esigenza CECOFLEX e CECOFLEX Plus sistemi di cablaggio flessibili e scatole di collegamento per le applicazioni di comunicazione e multimediali più importanti dello spazio abitativo.
Un unico sistema per ogni esigenza CECOFLEX e CECOFLEX Plus sistemi di cablaggio flessibili e scatole di collegamento per le applicazioni di comunicazione e multimediali più importanti dello spazio abitativo.
Imagicle Hotel. Guida alla configurazione delle centrali Siemens Hipath 2000/3000
 Imagicle Hotel. Guida alla configurazione delle centrali Siemens Hipath 2000/3000 2016 01/03/2016 2-17 www.imagicle.com Indice 1 CENTRALI SIEMENS SUPPORTATE.... 5 2 COME PROGRAMMARE LA CENTRALE PER L INTEGRAZIONE
Imagicle Hotel. Guida alla configurazione delle centrali Siemens Hipath 2000/3000 2016 01/03/2016 2-17 www.imagicle.com Indice 1 CENTRALI SIEMENS SUPPORTATE.... 5 2 COME PROGRAMMARE LA CENTRALE PER L INTEGRAZIONE
Utilizzo collegamento remoto
 Utilizzo collegamento remoto Introduzione Il collegamento VPN (virtual private network) consente a PC collegati ad internet ma fisicamente fuori dalla rete interna regionale, di accedere, con le credenziali
Utilizzo collegamento remoto Introduzione Il collegamento VPN (virtual private network) consente a PC collegati ad internet ma fisicamente fuori dalla rete interna regionale, di accedere, con le credenziali
MANUALE ISTRUZIONI PER UNA CORRETTA INSTALLAZIONE DEI MOTORI TUBOLARI ELETTRONICI
 MANUALE ISTRUZIONI PER UNA CORRETTA INSTALLAZIONE DEI MOTORI TUBOLARI ELETTRONICI www.bruelmotion.com SICUREZZA NOTE IMPORTANTE: Per garantire la sicurezza è necessario effettuare una corretta installazione,
MANUALE ISTRUZIONI PER UNA CORRETTA INSTALLAZIONE DEI MOTORI TUBOLARI ELETTRONICI www.bruelmotion.com SICUREZZA NOTE IMPORTANTE: Per garantire la sicurezza è necessario effettuare una corretta installazione,
MANUALE SID GESTIONE ESITI DI MIGRAZIONE PER MIT ANTI
 MANUALE SID GESTIONE ESITI DI MIGRAZIONE PER MIT ANTI 1 Premesse I file Esito di Migrazione che molti operatori hanno già ricevuto, si sono rivelati errati e non attendibili in quanto sono stati generati
MANUALE SID GESTIONE ESITI DI MIGRAZIONE PER MIT ANTI 1 Premesse I file Esito di Migrazione che molti operatori hanno già ricevuto, si sono rivelati errati e non attendibili in quanto sono stati generati
Imagicle Hotel. Guida alla configurazione delle centrali Alcatel OXO fino alla Rel. 4.x
 Imagicle Hotel. Guida alla configurazione delle centrali Alcatel OXO fino alla Rel. 4.x 2016 01/03/2016 2-14 www.imagicle.com Indice 1 CENTRALI ALCATEL SUPPORTATE... 5 2 COME PROGRAMMARE LA CENTRALE PER
Imagicle Hotel. Guida alla configurazione delle centrali Alcatel OXO fino alla Rel. 4.x 2016 01/03/2016 2-14 www.imagicle.com Indice 1 CENTRALI ALCATEL SUPPORTATE... 5 2 COME PROGRAMMARE LA CENTRALE PER
Manuale d uso TiSecurityBasic
 11/09-01-PC Software per la configurazione delle Centrali Antifurto 3485B e L/N/NT/HC/HS/HD4601 Manuale d uso TiSecurityBasic Versione 1.0 3 INDICE 1. Requisiti Hardware e Software 4 2. Installazione
11/09-01-PC Software per la configurazione delle Centrali Antifurto 3485B e L/N/NT/HC/HS/HD4601 Manuale d uso TiSecurityBasic Versione 1.0 3 INDICE 1. Requisiti Hardware e Software 4 2. Installazione
Versione Italiana. Introduzione. Contenuto della confezione. Importante! WC002 Sweex USB Webcam 100K with Microphone
 WC002 Sweex USB Webcam 100K with Microphone Introduzione Per prima cosa desideriamo ringraziarla vivamente per l acquisto della Sweex USB Webcam 100K with Microphone, la webcam che le renderà estremamente
WC002 Sweex USB Webcam 100K with Microphone Introduzione Per prima cosa desideriamo ringraziarla vivamente per l acquisto della Sweex USB Webcam 100K with Microphone, la webcam che le renderà estremamente
ISTRUZIONI USO E MONTAGGIO
 ISTRUZIONI USO E MONTAGGIO SISTEMA DI TRASMISSIONE DATI A MEZZO GSM PER DATALOGGER SERIE DL Leggere assolutamente le istruzioni d uso e di montaggio prima di procedere al posizionamento, all installazione
ISTRUZIONI USO E MONTAGGIO SISTEMA DI TRASMISSIONE DATI A MEZZO GSM PER DATALOGGER SERIE DL Leggere assolutamente le istruzioni d uso e di montaggio prima di procedere al posizionamento, all installazione
FAQ IRIDIUM GO! Servizio Clienti Intermatica -
 FAQ IRIDIUM GO! Sommario 1. A cosa serve l Iridium GO!?... 3 2. Quali sono le caratteristiche dell Iridium GO!?... 3 3. Come funziona l Iridium GO!?... 3 4. Quali sono le dimensioni ed il peso dell Iridium
FAQ IRIDIUM GO! Sommario 1. A cosa serve l Iridium GO!?... 3 2. Quali sono le caratteristiche dell Iridium GO!?... 3 3. Come funziona l Iridium GO!?... 3 4. Quali sono le dimensioni ed il peso dell Iridium
Sistemi di stampa a trasferimento termico
 Sistemi di stampa a trasferimento termico Sistemi di stampa a trasferimento termico Con i suoi diversi sistemi di stampa a trasferimento termico, ThermoTex offre numerose soluzioni per creare etichette
Sistemi di stampa a trasferimento termico Sistemi di stampa a trasferimento termico Con i suoi diversi sistemi di stampa a trasferimento termico, ThermoTex offre numerose soluzioni per creare etichette
AURORA WebDOC Document Management System
 AURORA WebDOC Document Management System PRESENTAZIONE Aurora WebDOC è un software della famiglia DMS (document management system) pensato per le piccole aziende e gli studi professionali. Queste realtà
AURORA WebDOC Document Management System PRESENTAZIONE Aurora WebDOC è un software della famiglia DMS (document management system) pensato per le piccole aziende e gli studi professionali. Queste realtà
Delibera AEEG 84/2012/R/EEL Art. 4, comma 1 lettera d)
 Adeguamento gamma SunEzy alla Delibera AEEG 84/2012/R/EEL Art. 4, comma 1 lettera d) SunEzy Control Version 1.3.0.1 Modifica delle soglie di frequenza e tensione Gli inverter della gamma SunEzy hanno al
Adeguamento gamma SunEzy alla Delibera AEEG 84/2012/R/EEL Art. 4, comma 1 lettera d) SunEzy Control Version 1.3.0.1 Modifica delle soglie di frequenza e tensione Gli inverter della gamma SunEzy hanno al
GUIDA RAPIDA PER INTERFACCIA UTENTE DELLA NOKIA OBSERVATION CAMERA
 GUIDA RAPIDA PER INTERFACCIA UTENTE DELLA NOKIA OBSERVATION CAMERA Copyright 2003 Nokia. Tutti i diritti sono riservati Data: 28.11.03, ver. 1.0 Indice 1. INTRODUZIONE...1 2. INSTALLAZIONE DEL SOFTWARE...1
GUIDA RAPIDA PER INTERFACCIA UTENTE DELLA NOKIA OBSERVATION CAMERA Copyright 2003 Nokia. Tutti i diritti sono riservati Data: 28.11.03, ver. 1.0 Indice 1. INTRODUZIONE...1 2. INSTALLAZIONE DEL SOFTWARE...1
EURO5 PASSTHRU RIPROGRAMMAZIONE DI CENTRALINE
 EURO5 PASSTHRU RIPROGRAMMAZIONE DI CENTRALINE ISTRUZIONI PER LA PROGRAMMAZIONE DI CENTRALINE CON OTC D650 (INSTALLAZIONE DEL SOFTWARE OTC PASSTHRU SU PC/LAPTOP E PROCEDURA DI PROGRAMMAZIONE) Info e Download
EURO5 PASSTHRU RIPROGRAMMAZIONE DI CENTRALINE ISTRUZIONI PER LA PROGRAMMAZIONE DI CENTRALINE CON OTC D650 (INSTALLAZIONE DEL SOFTWARE OTC PASSTHRU SU PC/LAPTOP E PROCEDURA DI PROGRAMMAZIONE) Info e Download
SOFTWARE DI GESTIONE DATI PULSOSSIMETRO PORTATILE SAT-500
 SOFTWARE DI GESTIONE DATI PULSOSSIMETRO PORTATILE SAT-500 Manuale di istruzioni Introduzione Il presente manuale è redatto in accordo alla direttiva CEE 93/42 sui dispositivi medici e ai relativi standard.
SOFTWARE DI GESTIONE DATI PULSOSSIMETRO PORTATILE SAT-500 Manuale di istruzioni Introduzione Il presente manuale è redatto in accordo alla direttiva CEE 93/42 sui dispositivi medici e ai relativi standard.
SISTEMA BUFALA DETECTOR BUFALE IDENTIFICATE E TRACCIATE PER UNA PRODUZIONE PIÙ SICURA
SISTEMA BUFALA DETECTOR BUFALE IDENTIFICATE E TRACCIATE PER UNA PRODUZIONE PIÙ SICURA Fotografia: Caseificio Barlotti Paestum L UNESCO HA ISCRITTO NELLE LISTE DEL PATRIMONIO IMMATERIALE DELL UMANITÀ LA
SISTEMA BUFALA DETECTOR BUFALE IDENTIFICATE E TRACCIATE PER UNA PRODUZIONE PIÙ SICURA Fotografia: Caseificio Barlotti Paestum L UNESCO HA ISCRITTO NELLE LISTE DEL PATRIMONIO IMMATERIALE DELL UMANITÀ LA
Xerox FreeFlow Print Server V 9.0 SP3
 FreeFlow Print Server V9 SP3 Novembre 2012 708P90226 Xerox FreeFlow Print Server V 9.0 SP3 Pacchetto di benvenuto per i sistemi Xerox Color 550/560, Xerox 700 e 770 Digital Color e Xerox J75 e C75 Digital
FreeFlow Print Server V9 SP3 Novembre 2012 708P90226 Xerox FreeFlow Print Server V 9.0 SP3 Pacchetto di benvenuto per i sistemi Xerox Color 550/560, Xerox 700 e 770 Digital Color e Xerox J75 e C75 Digital
Manuale utente AA
 Manuale utente AA 10.2016 Sommario Avvertenze generali... 3 Presentazione IrDA6000... 3 Collegamento IrDA6000 ai sistemi di pagamento Paytec... 4 Impostazione sul sistema Paytec... 4 Diagnostica... 5 Caratteristiche
Manuale utente AA 10.2016 Sommario Avvertenze generali... 3 Presentazione IrDA6000... 3 Collegamento IrDA6000 ai sistemi di pagamento Paytec... 4 Impostazione sul sistema Paytec... 4 Diagnostica... 5 Caratteristiche
NOTE INSTALLAZIONE AGGIORNAMENTO Versione
 NOTE INSTALLAZIONE AGGIORNAMENTO Versione 9.7.180 CONTROLLI DA ESEGUIRE PRIMA DELL'AGGIORNAMENTO La presente versione non è più compatibile con Windows 98, pertanto in presenza di questo sistema operativo
NOTE INSTALLAZIONE AGGIORNAMENTO Versione 9.7.180 CONTROLLI DA ESEGUIRE PRIMA DELL'AGGIORNAMENTO La presente versione non è più compatibile con Windows 98, pertanto in presenza di questo sistema operativo
E l ora di Caesium! In questo numero. Indice
 Numero 3 Numero - 2011 1 - Anno 2010 Via Luigi Dalla Via, 10-36015 Schio (VI) Tel. 0445 502811 - Fax 0445 502999 E-mail [email protected] - www.coges.eu E l ora di Caesium! Il nuovo riconoscitore di monete
Numero 3 Numero - 2011 1 - Anno 2010 Via Luigi Dalla Via, 10-36015 Schio (VI) Tel. 0445 502811 - Fax 0445 502999 E-mail [email protected] - www.coges.eu E l ora di Caesium! Il nuovo riconoscitore di monete
Sistema acquisizione dati trasportabile per macchine operatrici. 1/5 www.ni.com
 Sistema acquisizione dati trasportabile per macchine operatrici "Grazie anche alle contenute dimensioni del CompactRIO e alla sua robustezza e resistenza meccanica e ambientale, è stato possibile realizzare
Sistema acquisizione dati trasportabile per macchine operatrici "Grazie anche alle contenute dimensioni del CompactRIO e alla sua robustezza e resistenza meccanica e ambientale, è stato possibile realizzare
Rete Sicura Plus. Guida d installazione ed attivazione del servizio
 Rete Sicura Plus Guida d installazione ed attivazione del servizio Come avviare l'installazione Per installare il prodotto, sono necessari: a. Una connessione internet b. Una chiave di abbonamento valida
Rete Sicura Plus Guida d installazione ed attivazione del servizio Come avviare l'installazione Per installare il prodotto, sono necessari: a. Una connessione internet b. Una chiave di abbonamento valida
TERMOMETRO PALMARE MULTISONDA
 ECONORMA S.a.s. Prodotti e Tecnologie per l Ambiente 31020 S. VENDEMIANO - TV - Via Olivera 52 - ITALY Tel. 0438-409049 E-Mail: [email protected] www.econorma.com TERMOMETRO PALMARE MULTISONDA FT-Reader/TE
ECONORMA S.a.s. Prodotti e Tecnologie per l Ambiente 31020 S. VENDEMIANO - TV - Via Olivera 52 - ITALY Tel. 0438-409049 E-Mail: [email protected] www.econorma.com TERMOMETRO PALMARE MULTISONDA FT-Reader/TE
Assemblea X DataNet S.r.l.
 Assemblea è una soluzione che permette di gestire in modo completo ed efficiente le assemblee soci nelle società ad azionariato diffuso come banche, aziende, cooperative e consorzi. www.xdatanet.com Un
Assemblea è una soluzione che permette di gestire in modo completo ed efficiente le assemblee soci nelle società ad azionariato diffuso come banche, aziende, cooperative e consorzi. www.xdatanet.com Un
Trail camera di ultima generazione in grado di inviare SMS MMS
 PHOTO FAUNA BG-520 BG-520M BG-520SM Trail camera di ultima generazione in grado di inviare SMS MMS E-MAIL ATTENZIONE : PRIMA DI PROCEDERE CON L'UTILIZZO DEL PROGRAMMA DOVETE FORMATTARE LA SCHEDA DI MEMORIA
PHOTO FAUNA BG-520 BG-520M BG-520SM Trail camera di ultima generazione in grado di inviare SMS MMS E-MAIL ATTENZIONE : PRIMA DI PROCEDERE CON L'UTILIZZO DEL PROGRAMMA DOVETE FORMATTARE LA SCHEDA DI MEMORIA
Processore audio Plantronics DA80. Guida dell'utente
 Processore audio Plantronics DA80 Guida dell'utente Sommario Introduzione 3 Potenza 4 Software Plantronics Spokes 5 Installazione di Plantronics Hub 5 Avvio di Hub 5 Schede Hub 5 Utilizzare la cuffia 6
Processore audio Plantronics DA80 Guida dell'utente Sommario Introduzione 3 Potenza 4 Software Plantronics Spokes 5 Installazione di Plantronics Hub 5 Avvio di Hub 5 Schede Hub 5 Utilizzare la cuffia 6
Hiab XS 044 Gamma 3,7 4,0 tm
 Hiab XS 044 Gamma 3,7 4,0 tm Opuscolo del prodotto Fornisce uno sbraccio eccellente La Hiab XS 044 è una gru davvero completa Il nome Hiab è da sempre associato a qualità elevata e miglioramenti continui.
Hiab XS 044 Gamma 3,7 4,0 tm Opuscolo del prodotto Fornisce uno sbraccio eccellente La Hiab XS 044 è una gru davvero completa Il nome Hiab è da sempre associato a qualità elevata e miglioramenti continui.
TERMINALE DI RILEVAZIONE PRESENZE E CONTROLLO ACCESSI CON LETTORE DI IMPRONTE DIGITALI E TESSERE RFID, MOD. SVAR2-FINGER CON ADATTATORE WI-FI ESTERNO
 TERMINALE DI RILEVAZIONE PRESENZE E CONTROLLO ACCESSI CON LETTORE DI IMPRONTE DIGITALI E TESSERE RFID, MOD. SVAR2-FINGER CON ADATTATORE WI-FI ESTERNO 1 SVAR2-FINGER è un terminale di rilevazione presenze
TERMINALE DI RILEVAZIONE PRESENZE E CONTROLLO ACCESSI CON LETTORE DI IMPRONTE DIGITALI E TESSERE RFID, MOD. SVAR2-FINGER CON ADATTATORE WI-FI ESTERNO 1 SVAR2-FINGER è un terminale di rilevazione presenze
GUIDA DI AVVIO RAPIDO. Contenuto della confezione. Requisiti di sistema. Supporto support.datacolor.com
 GUIDA DI AVVIO RAPIDO Contenuto della confezione Istruzioni per il download di Spyder5ELITE+ Numero di serie Requisiti di sistema Windows 7 32/64, Windows 8.0, 8.1 32/64, 10 32/64 Mac OS X 10.7, 10.8,
GUIDA DI AVVIO RAPIDO Contenuto della confezione Istruzioni per il download di Spyder5ELITE+ Numero di serie Requisiti di sistema Windows 7 32/64, Windows 8.0, 8.1 32/64, 10 32/64 Mac OS X 10.7, 10.8,
Easi-View. Garanzia e assistenza. Supporto tecnico
 Garanzia e assistenza Questo prodotto viene fornito con una garanzia di un anno per i problemi riscontrati durante il normale utilizzo. Un cattivo uso di Easi-View o l'apertura dell'unità renderanno nulla
Garanzia e assistenza Questo prodotto viene fornito con una garanzia di un anno per i problemi riscontrati durante il normale utilizzo. Un cattivo uso di Easi-View o l'apertura dell'unità renderanno nulla
Gestione della memoria
 Memoria della stampante 1 La stampante viene fornita con almeno 64 MB di memoria. Per stabilire la quantità di memoria attualmente installata nella stampante, selezionare Stampa menu dal menu Utilità.
Memoria della stampante 1 La stampante viene fornita con almeno 64 MB di memoria. Per stabilire la quantità di memoria attualmente installata nella stampante, selezionare Stampa menu dal menu Utilità.
Nuove Funzionalità CAS genesisworld x8
 Nuove Funzionalità CAS genesisworld x8 Customer Centricity CERTIFIED xrm e CRM per le PMI CAS genesisworld x8: Customer Centricity migliora la Customer Experience I nuovi standard della versione x8 di
Nuove Funzionalità CAS genesisworld x8 Customer Centricity CERTIFIED xrm e CRM per le PMI CAS genesisworld x8: Customer Centricity migliora la Customer Experience I nuovi standard della versione x8 di
Backup e ripristino Guida per l'utente
 Backup e ripristino Guida per l'utente Copyright 2008 Hewlett-Packard Development Company, L.P. Windows è un marchio registrato negli Stati Uniti di Microsoft Corporation. Le informazioni contenute in
Backup e ripristino Guida per l'utente Copyright 2008 Hewlett-Packard Development Company, L.P. Windows è un marchio registrato negli Stati Uniti di Microsoft Corporation. Le informazioni contenute in
Internetworking V a nno
 Internetworking V anno Introduzione ad Arduino Introduzione La scheda Arduino nasce nel 2005 dall idea di alcuni giovani ricercatori guidati da Massimo Banzi. Il loro obiettivo era quello di creare una
Internetworking V anno Introduzione ad Arduino Introduzione La scheda Arduino nasce nel 2005 dall idea di alcuni giovani ricercatori guidati da Massimo Banzi. Il loro obiettivo era quello di creare una
Ricevitore Supervisionato RX-24
 Ricevitore Supervisionato RX-24 Dati tecnici Gestione a microprocessore 24 Sensori memorizzabili 8 Uscite allarme uno per canale 8 Canali con 3 sensori per ogni canale 10 Telecomandi programmabili 1 Uscita
Ricevitore Supervisionato RX-24 Dati tecnici Gestione a microprocessore 24 Sensori memorizzabili 8 Uscite allarme uno per canale 8 Canali con 3 sensori per ogni canale 10 Telecomandi programmabili 1 Uscita
Installazione di Sigla Ultimate
 Installazione di Sigla Ultimate Importante : Prima di effettuare l aggiornamento di sigla effettuare un backup Non deve essere utilizzato sigla durante l installazione dell aggiornamento Primi passi :
Installazione di Sigla Ultimate Importante : Prima di effettuare l aggiornamento di sigla effettuare un backup Non deve essere utilizzato sigla durante l installazione dell aggiornamento Primi passi :
Compatto, innovativo ed economico!! Data Logger. ECONORMA S.a.s. TEMPERATURA - UMIDITA RELATIVA % SOFTWARE
 Data Logger FT-90/USB Compatto, innovativo ed economico!! TEMPERATURA - UMIDITA RELATIVA % CARATTERISTICHE TECNICHE Numero di matricola: univoco con descrizione della missione. Memoria dati: 245.000 letture.
Data Logger FT-90/USB Compatto, innovativo ed economico!! TEMPERATURA - UMIDITA RELATIVA % CARATTERISTICHE TECNICHE Numero di matricola: univoco con descrizione della missione. Memoria dati: 245.000 letture.
Telelettura contatori acqua
 Telelettura contatori acqua SRC ELECTRONIC SISTEMA 2011 Sistema. I sistemi di telelettura sono di 2 tipi : - Centralizzato Consiste nella raccolta dei dati direttamente in un database centrale grazie alla
Telelettura contatori acqua SRC ELECTRONIC SISTEMA 2011 Sistema. I sistemi di telelettura sono di 2 tipi : - Centralizzato Consiste nella raccolta dei dati direttamente in un database centrale grazie alla
Palina elettronica per la misurazione e trasmissione in tempo reale di parametri del manto nevoso nelle zone di distacco delle valanghe
 Palina elettronica per la misurazione e trasmissione in tempo reale di parametri del manto nevoso nelle zone di distacco delle valanghe Brevetto Depositato Motivazioni è molto importante conoscere l evoluzione
Palina elettronica per la misurazione e trasmissione in tempo reale di parametri del manto nevoso nelle zone di distacco delle valanghe Brevetto Depositato Motivazioni è molto importante conoscere l evoluzione
Aggiornamento dei dati dell obiettivo per il controllo distorsione
 Aggiornamento dei dati dell obiettivo per il controllo distorsione Grazie per avere acquistato un prodotto Nikon. In questa guida viene descritto come eseguire l aggiornamento dei dati dell obiettivo per
Aggiornamento dei dati dell obiettivo per il controllo distorsione Grazie per avere acquistato un prodotto Nikon. In questa guida viene descritto come eseguire l aggiornamento dei dati dell obiettivo per
Gruppi di continuità per applicazioni SO-HO
 IT LINE INTERACTIVE VI Gruppi di continuità per applicazioni SO-HO Il problema della qualità dell alimentazione elettrica e delle interruzioni di rete è ormai all ordine del giorno, coinvolge tutte le
IT LINE INTERACTIVE VI Gruppi di continuità per applicazioni SO-HO Il problema della qualità dell alimentazione elettrica e delle interruzioni di rete è ormai all ordine del giorno, coinvolge tutte le
Aggiornamenti del software Guida per l utente
 Aggiornamenti del software Guida per l utente Copyright 2009 Hewlett-Packard Development Company, L.P. Windows è un marchio registrato negli Stati Uniti di Microsoft Corporation. Le informazioni contenute
Aggiornamenti del software Guida per l utente Copyright 2009 Hewlett-Packard Development Company, L.P. Windows è un marchio registrato negli Stati Uniti di Microsoft Corporation. Le informazioni contenute
CATALOGO RIPARAZIONI SISTEMI DI PAGAMENTO E SCHEDE
 CATALOGO RIPARAZIONI Sommario SISTEMI DI PAGAMENTO 3 PRODOTTI AZKOYEN... 3 PRODOTTI COGES... 3 PRODOTTI COMESTERO... 6 PRODOTTI FAGE... 8 PRODOTTI ICT... 9 PRODOTTI MEI... 10 PRODOTTI NECTA... 12 PRODOTTI
CATALOGO RIPARAZIONI Sommario SISTEMI DI PAGAMENTO 3 PRODOTTI AZKOYEN... 3 PRODOTTI COGES... 3 PRODOTTI COMESTERO... 6 PRODOTTI FAGE... 8 PRODOTTI ICT... 9 PRODOTTI MEI... 10 PRODOTTI NECTA... 12 PRODOTTI
CONTROLLORI DA INCASSO PER SISTEMI DI ASPIRAZIONE PROFESSIONALI E INDUSTRIALI
 CONTROLLORI DA INCASSO PER SISTEMI DI ASPIRAZIONE PROFESSIONALI E INDUSTRIALI CONTROLLORI DA INCASSO PER SISTEMI DI ASPIRAZIONE PROFESSIONALI E INDUSTRIALI Destinati al settore dell aspirazione professionale
CONTROLLORI DA INCASSO PER SISTEMI DI ASPIRAZIONE PROFESSIONALI E INDUSTRIALI CONTROLLORI DA INCASSO PER SISTEMI DI ASPIRAZIONE PROFESSIONALI E INDUSTRIALI Destinati al settore dell aspirazione professionale
Archiviazione Elettronica e Conservazione sostitutiva
 ACO Archiviazione Elettronica e Conservazione sostitutiva Giugno 2015 INDICE A) INSTALLAZIONE DELL AGGIORNAMENTO... 2 AGGIORNAMENTO STAND ALONE/SERVER... 2 AGGIORNAMENTO CLIENT... 4 B) CONSERVAZIONE IN
ACO Archiviazione Elettronica e Conservazione sostitutiva Giugno 2015 INDICE A) INSTALLAZIONE DELL AGGIORNAMENTO... 2 AGGIORNAMENTO STAND ALONE/SERVER... 2 AGGIORNAMENTO CLIENT... 4 B) CONSERVAZIONE IN
I-SD01. Selezionatore vocale. Guida all installazione e alla programmazione
 I-SD01 Selezionatore vocale Guida all installazione e alla programmazione Introduzione Il modulo I-SD01 è progettato e realizzato per potere essere installato sull unità di controllo I-ON16. L I-SD01 consente
I-SD01 Selezionatore vocale Guida all installazione e alla programmazione Introduzione Il modulo I-SD01 è progettato e realizzato per potere essere installato sull unità di controllo I-ON16. L I-SD01 consente
TERMINALE DI RILEVAZIONE PRESENZE E CONTROLLO ACCESSI CON LETTORE DI IMPRONTE DIGITALI E TESSERE RFID, MOD
 TERMINALE DI RILEVAZIONE PRESENZE E CONTROLLO ACCESSI CON LETTORE DI IMPRONTE DIGITALI E TESSERE RFID, MOD. SAODY-FINGER/P CON SOFTWARE IN VERSIONE PROFESSIONAL E WEB SERVER INTEGRATO 1 SAODY-FINGER/P
TERMINALE DI RILEVAZIONE PRESENZE E CONTROLLO ACCESSI CON LETTORE DI IMPRONTE DIGITALI E TESSERE RFID, MOD. SAODY-FINGER/P CON SOFTWARE IN VERSIONE PROFESSIONAL E WEB SERVER INTEGRATO 1 SAODY-FINGER/P
GUIDA UTENTE Easi-View Condividere il lavoro con tutta la classe, visualizzare oggetti in 3D e riprendere foto e video
 GUIDA UTENTE www.tts-shopping.com Easi-View Condividere il lavoro con tutta la classe, visualizzare oggetti in 3D e riprendere foto e video Informazioni importanti n Conservare queste istruzioni per riferimento
GUIDA UTENTE www.tts-shopping.com Easi-View Condividere il lavoro con tutta la classe, visualizzare oggetti in 3D e riprendere foto e video Informazioni importanti n Conservare queste istruzioni per riferimento
Pulsante d allarme. Contact GSM-1M. Il Passaporto. Il numero di riferimento del dispositivo
 Pulsante d allarme Contact GSM-1M Il Passaporto Il numero di riferimento del dispositivo 1. Dati generali Il pulsante d allarme Contact GSM -1M (in seguito - il dispositivo) è destinata per formare gli
Pulsante d allarme Contact GSM-1M Il Passaporto Il numero di riferimento del dispositivo 1. Dati generali Il pulsante d allarme Contact GSM -1M (in seguito - il dispositivo) è destinata per formare gli
LG K10, K8 e K4 (2017): batterie potenziate, migliori fotocamere e design più elegante - Notebook Italia
 La nuova serie K punta direttamente all essenziale per offrire un esperienza d uso semplice ma assolutamente completa, arricchendosi anche di funzionalità tratte direttamente dalla fascia più alta del
La nuova serie K punta direttamente all essenziale per offrire un esperienza d uso semplice ma assolutamente completa, arricchendosi anche di funzionalità tratte direttamente dalla fascia più alta del
TELEVIVAVOCE 7IS /03/2015
 TELEVIVAVOCE 7IS-80278 06/03/2015 TELEVIVAVOCE Televivavoce è un telefono vivavoce automatico che permette la comunicazione vocale con un numero programmabile alla sola pressione del relativo pulsante.
TELEVIVAVOCE 7IS-80278 06/03/2015 TELEVIVAVOCE Televivavoce è un telefono vivavoce automatico che permette la comunicazione vocale con un numero programmabile alla sola pressione del relativo pulsante.
ST 600. Telefono di sistema. Posto Operatore di ultima generazione gestibile da PC. Funzioni principali
 Telefoni ST 600 Telefono di sistema Posto Operatore di ultima generazione gestibile da PC Il telefono ST 600 viene fornito con il software Personal Phone Suite e il cavo USB, a garanzia della perfetta
Telefoni ST 600 Telefono di sistema Posto Operatore di ultima generazione gestibile da PC Il telefono ST 600 viene fornito con il software Personal Phone Suite e il cavo USB, a garanzia della perfetta
